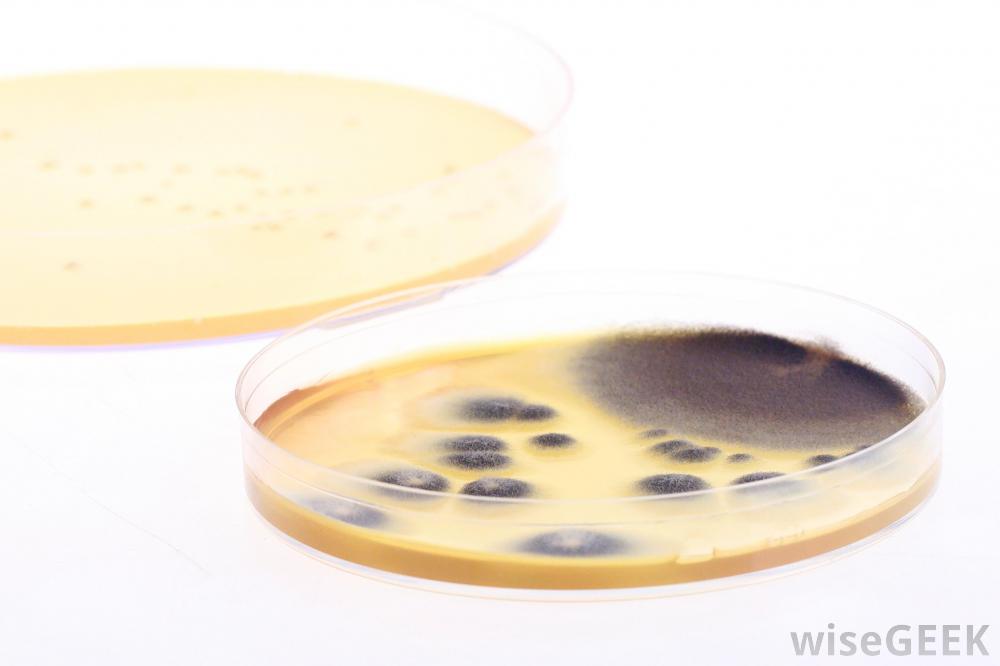

关于细菌鉴定我应该知道些什么(What Should I Know About Bacterial Identification)?
细菌鉴定是用来确定特定细菌的身份的过程,它是医学治疗的重要组成部分,因为许多治疗方法都严重依赖于某一特定有机体的身份,从而导致医学问题,它也是科学研究的一个重要组成部分。许多技术被用于细菌鉴定,随着人们对细菌的...
细菌鉴定是用来确定特定细菌的身份的过程,它是医学治疗的重要组成部分,因为许多治疗方法都严重依赖于某一特定有机体的身份,从而导致医学问题,它也是科学研究的一个重要组成部分。许多技术被用于细菌鉴定,随着人们对细菌的了解和新的医疗设备的开发,新的技术也在不断地被设计出来src="/img/0725/plate-culture.jpg"/>细菌鉴定是医学治疗的重要组成部分。细菌鉴定的第一步是建立一个分离物,有关细菌的有效样本。从病人或物体上取一小块可疑细菌开始分离。分离物是通过找到一种能支持细菌的生长培养基,并成功培养出足够多用于研究的细菌而产生的。这是一个真正的挑战,由于细菌非常挑剔,它们不会在任何培养基中生长,因此避免污染生长培养基或样本也很重要,因为这可能会导致混淆的结果。 在实验室结果出来之前,从喉咙后部采集的样本可以生长几天一旦细菌被培养出来,各种各样的工具就可以用来为它的身份提供线索。最基本的一种是革兰氏染色法,它用化学染色法将细菌分为革兰氏阳性菌和革兰氏阴性菌。其他染色剂可以用来增强对比度,使细菌更容易在显微镜下看到。显微镜下的视觉鉴定通常可以通过熟悉的细菌种类来完成,特别是那些形状独特的。细菌鉴定库里有更多的工具。研究人员可以使用血清学方法,基因测序包括将一个未知细菌的样本暴露于各种抗体中,看看是否有一种反应或基因测序,在这种反应中,细菌的遗传密码被解开。基因测序还可以用来区分两种密切相关的细菌菌株,提供一种菌株对某一种特定菌株产生反应的原因药物治疗的过程,而另一个没有。也可以研究对各种化学物质和刺激的反应,如紫外线辐射。细菌鉴定通常在实验室进行,因为实验室有医疗设备、化学药品和在追踪细菌身份过程中使用的工具。一些实验室专门培养和鉴定医院和诊所的样本,而其他实验室则专注于研究,识别新的和未知的细菌样本,以便对它们进行分类严格控制实验室环境,防止实验室工作人员受到污染和意外感染,在高安全性的实验室里,科学家们正在研究具有特殊毒性的生物体,这些实验室为科学家们提供了几层保护。
在实验室结果出来之前,从喉咙后部采集的样本可以生长几天一旦细菌被培养出来,各种各样的工具就可以用来为它的身份提供线索。最基本的一种是革兰氏染色法,它用化学染色法将细菌分为革兰氏阳性菌和革兰氏阴性菌。其他染色剂可以用来增强对比度,使细菌更容易在显微镜下看到。显微镜下的视觉鉴定通常可以通过熟悉的细菌种类来完成,特别是那些形状独特的。细菌鉴定库里有更多的工具。研究人员可以使用血清学方法,基因测序包括将一个未知细菌的样本暴露于各种抗体中,看看是否有一种反应或基因测序,在这种反应中,细菌的遗传密码被解开。基因测序还可以用来区分两种密切相关的细菌菌株,提供一种菌株对某一种特定菌株产生反应的原因药物治疗的过程,而另一个没有。也可以研究对各种化学物质和刺激的反应,如紫外线辐射。细菌鉴定通常在实验室进行,因为实验室有医疗设备、化学药品和在追踪细菌身份过程中使用的工具。一些实验室专门培养和鉴定医院和诊所的样本,而其他实验室则专注于研究,识别新的和未知的细菌样本,以便对它们进行分类严格控制实验室环境,防止实验室工作人员受到污染和意外感染,在高安全性的实验室里,科学家们正在研究具有特殊毒性的生物体,这些实验室为科学家们提供了几层保护。 熟悉的细菌通常可以通过形状来识别。
熟悉的细菌通常可以通过形状来识别。
 在实验室结果出来之前,从喉咙后部采集的样本可以生长几天一旦细菌被培养出来,各种各样的工具就可以用来为它的身份提供线索。最基本的一种是革兰氏染色法,它用化学染色法将细菌分为革兰氏阳性菌和革兰氏阴性菌。其他染色剂可以用来增强对比度,使细菌更容易在显微镜下看到。显微镜下的视觉鉴定通常可以通过熟悉的细菌种类来完成,特别是那些形状独特的。细菌鉴定库里有更多的工具。研究人员可以使用血清学方法,基因测序包括将一个未知细菌的样本暴露于各种抗体中,看看是否有一种反应或基因测序,在这种反应中,细菌的遗传密码被解开。基因测序还可以用来区分两种密切相关的细菌菌株,提供一种菌株对某一种特定菌株产生反应的原因药物治疗的过程,而另一个没有。也可以研究对各种化学物质和刺激的反应,如紫外线辐射。细菌鉴定通常在实验室进行,因为实验室有医疗设备、化学药品和在追踪细菌身份过程中使用的工具。一些实验室专门培养和鉴定医院和诊所的样本,而其他实验室则专注于研究,识别新的和未知的细菌样本,以便对它们进行分类严格控制实验室环境,防止实验室工作人员受到污染和意外感染,在高安全性的实验室里,科学家们正在研究具有特殊毒性的生物体,这些实验室为科学家们提供了几层保护。
在实验室结果出来之前,从喉咙后部采集的样本可以生长几天一旦细菌被培养出来,各种各样的工具就可以用来为它的身份提供线索。最基本的一种是革兰氏染色法,它用化学染色法将细菌分为革兰氏阳性菌和革兰氏阴性菌。其他染色剂可以用来增强对比度,使细菌更容易在显微镜下看到。显微镜下的视觉鉴定通常可以通过熟悉的细菌种类来完成,特别是那些形状独特的。细菌鉴定库里有更多的工具。研究人员可以使用血清学方法,基因测序包括将一个未知细菌的样本暴露于各种抗体中,看看是否有一种反应或基因测序,在这种反应中,细菌的遗传密码被解开。基因测序还可以用来区分两种密切相关的细菌菌株,提供一种菌株对某一种特定菌株产生反应的原因药物治疗的过程,而另一个没有。也可以研究对各种化学物质和刺激的反应,如紫外线辐射。细菌鉴定通常在实验室进行,因为实验室有医疗设备、化学药品和在追踪细菌身份过程中使用的工具。一些实验室专门培养和鉴定医院和诊所的样本,而其他实验室则专注于研究,识别新的和未知的细菌样本,以便对它们进行分类严格控制实验室环境,防止实验室工作人员受到污染和意外感染,在高安全性的实验室里,科学家们正在研究具有特殊毒性的生物体,这些实验室为科学家们提供了几层保护。 熟悉的细菌通常可以通过形状来识别。
熟悉的细菌通常可以通过形状来识别。
- 发表于 2020-07-25 14:39
- 阅读 ( 840 )
- 分类:医疗卫生
你可能感兴趣的文章
- 木贼是什么(Equisetum Arvense)? 972 浏览
- 什么是多产性咳嗽(Productive Cough)? 1135 浏览
- 金合欢的医学用途是什么(Medical Uses of Acacia Concinna)? 1130 浏览
- 什么是汞合金纹身(Amalgam Tattoo)? 1029 浏览
- 我该如何治疗干性高跟鞋(Treat Dry Heels)? 1001 浏览
- 什么是生殖器疣(Genital Warts)? 888 浏览
- 疱疹样皮炎有哪些不同的治疗方法(Different Types of Dermatitis Herpetiformis Treatment)? 815 浏览
- 什么是过敏原(Allergen)? 1162 浏览
- 什么是CPAP加湿器(CPAP Humidifier)? 1007 浏览
- 什么是救护车(Ambulance)? 1366 浏览
- 什么是边缘人格障碍治疗(Borderline Personality Disorder Therapy)? 1031 浏览
- 什么是抗利尿激素(Antidiuretic Hormone)? 1207 浏览
- 多动症的辅助技术有哪些(Different Types of Assistive Technology for ADHD)? 821 浏览
- 什么是Tenesmus(Tenesmus)? 868 浏览
- 抗生素对耐甲氧西林金黄色葡萄球菌有多有效(Effective are Antibiotics for MRSA)? 838 浏览
- 什么是免疫缺陷(Immune Deficiency)? 1403 浏览
- 什么是舌骨切除术(Glossectomy)? 631 浏览
- 什么是指关节炎(Dactylitis)? 914 浏览
- 什么是喷他脒(Pentamidine)? 2769 浏览
- 什么是引导组织再生(Guided Tissue Regeneration)? 1497 浏览
- 什么是驱虫药(Anthelmintics)? 1194 浏览
- 我如何开始我自己的网上药店业务(Start my Own Online Pharmacy Business)? 811 浏览
- 创伤后应激障碍咨询涉及哪些内容(Involved in PTSD Counseling)? 752 浏览
- 什么是辐射物理学(Radiation Physics)? 1219 浏览
- 怎样才能使静脉曲张最小化(Minimize Varicose Veins)? 711 浏览
- 什么是口服生物利用度(Oral Bioavailability)? 5823 浏览
- 安非他明和甲基苯丙胺有什么区别(Difference Between Amphetamine and Methamphetamine)? 2374 浏览
- 什么是血精(Hematospermia)? 1041 浏览
- 什么是双胍(Biguanides)? 976 浏览
- 什么是内眦褶(Epicanthal Folds)? 2028 浏览
相关问题
0 条评论
请先 登录 后评论
admin
0 篇文章
作家榜 »
-
 xiaonan123
189 文章
xiaonan123
189 文章
-
 汤依妹儿
97 文章
汤依妹儿
97 文章
-
 luogf229
46 文章
luogf229
46 文章
-
 jy02406749
45 文章
jy02406749
45 文章
-
 小凡
34 文章
小凡
34 文章
-
 Daisy萌
32 文章
Daisy萌
32 文章
-
 我的QQ3117863681
24 文章
我的QQ3117863681
24 文章
-
 华志健
23 文章
华志健
23 文章
推荐文章
- 有哪些不同类型的核医学扫描(Different Types of Nuclear Medicine Scans)?
- 西替利嗪对儿童安全吗(Safe Is Cetirizine for Children)?
- 什么是红色粟粒疹(Miliaria Rubra)?
- 什么是胃造瘘管(Gastrostomy Tube)?
- 创伤后应激障碍与双极性精神障碍之间有什么联系(the Connection between PTSD and Bipolar)?
- 什么是阿片类镇痛药(What Opioid Analgesics)?
- 如何解释我的腰椎穿刺结果(Interpret My Lumbar Puncture Results)?
- 什么是Vimax(Vimax)?
- 认知和情感之间有什么联系(the Connection between Cognition and Emotion)?
- 什么是时间疗法(Chronotherapy)?
- 甲状旁腺激素升高有什么影响(Effects of Elevated Parathyroid Hormone)?
- 什么是吸气器(Aspirator)?
- 脑脊液开启压力是多少(CSF Opening Pressure)?
- 柴洋的医疗好处是什么(Medical Benefits of Chai-Yok)?
- 什么是健康感知(Health Perception)?
- 什么是Nganga(Nganga)?
- 什么是受精(Insemination)?
- 我如何参加医疗补助(Enroll in Medicaid)?
- 什么是个人苦恼(Personal Distress)?
- 为什么术后住院时间变得这么短(Hospital Stays After Surgery Become so Short)?
- 轴突损伤有哪些类型(Different Types of Axon Damage)?
- 服用对乙酰氨基酚和可待因的利弊是什么(Pros and Cons of Taking Acetaminophen and Codeine)?
- 什么是改良吞钡剂(Modified Barium Swallow)?
- 什么是草莓(Fragaria Vesca)?
- 什么是人生转折(Life Transition)?
- 吡格列酮对糖尿病有多有效(Effective Is Pioglitazone for Diabetes)?
- 什么导致脖子僵硬发烧(What Causes a Stiff Neck and Fever)?
- 什么是雾化面罩(Nebulizer Mask)?
- 什么是预期社会化(Anticipatory Socialization)?
- 什么是提示发音(Cued Articulation)?